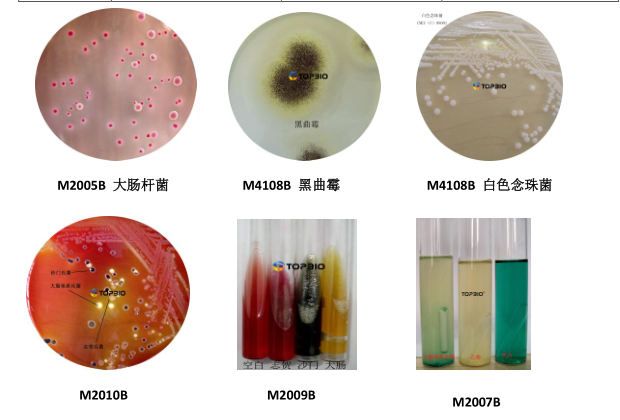

- 定做培养基/定制培养基
- 颗粒培养基
- 标准菌株生化鉴定试剂盒
- 预灌装即用型成品培养基
- 2025年版中国药典
- 促销/特价商品
- 院感/疾控/体外诊断/采样管
- 样品采集与处理(均质)产品
- 按标准检索培养基
- 模拟灌装用培养基
- 干燥粉末培养基
- 培养基添加剂/补充剂
- 生化反应鉴定管
- 染色液等配套产品
- 对照培养基/标准品
- 实验耗材与器具
- 生化试剂/化学试剂
- 菌种鉴定服务
技术资料
您现在的位置: 网站首页 >> 技术资料
培养基在适用性检查及方法验证中需要接种的微生物
[所属分类:技术资料] [发布时间:2019-8-14] [发布人:] [阅读次数:] [返回]
山东拓普生物工程有限公司
Shandong Tuopu Biol-Engineering Co.,Ltd